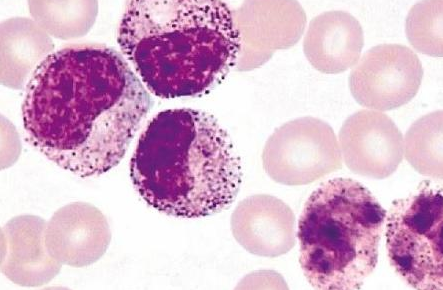

治疗慢性淋巴细胞白血病的药物有哪些?用于治疗慢性淋巴细胞白血病的药物有三种类型,包括化疗药物尼莫司汀、氟达拉滨和苯丁酸氮芥,靶向药物艾德拉尼、维奈妥拉及依鲁替尼、靶向单克隆抗体奥法木单抗、利妥昔单抗、阿托珠单抗和阿仑珠单抗等。
依鲁替尼是一种口服布鲁顿酪氨酸激酶抑制剂,可拮抗B细胞受体、趋化因子和整合素介导的信号。在早期研究中,证实依鲁替尼具有高缓解率,并能延长慢性淋巴细胞白血病(CLL)的无进展生存期(PFS)。
依鲁替尼,也称为伊布替尼,是一种新型口服靶向药物,可选择性抑制布鲁顿复合氨基酸激酶。依鲁替尼也是世界上第一个上市的BTK抑制剂。它于2013年11月被美国食品和药物管理局批准。
2017年8月,依鲁替尼通过国家食品药品监督管理局在中国上市,用于治疗之前至少接受过一次治疗的慢性淋巴细胞白血病(CLL)/小淋巴细胞淋巴瘤(SLL)和套细胞淋巴瘤患者。
一种药物的好坏取决于它的疗效。依鲁替尼的两项为期5年的随访研究结果发表在ASH2016上。两者都表明,CLL/SLL患者越早使用依鲁替尼,生存受益越大。依鲁替尼治疗新诊断、复发和难治性CLL患者的结果显示,客观缓解率ORR显著提高,中位PFS显著延长,且与化疗药物相比,依鲁替尼可改善患者的血象。
依鲁替尼药品详细信息请进入:https://www.inmedf.com/zhongliu/lin/2019127.html
此外,对于慢性淋巴细胞白血病(CLL)患者,无论他们是标准风险患者、重病患者还是没有有效治疗方法的患者,依鲁替尼治疗可用于延长生存期并获得长期生存的权利。